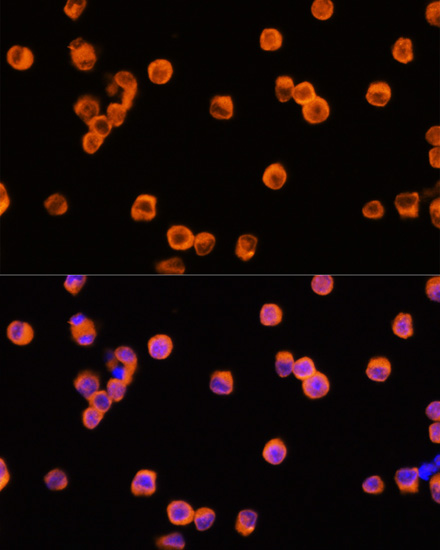
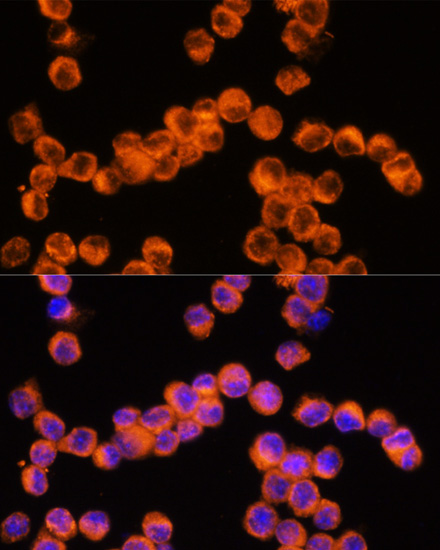
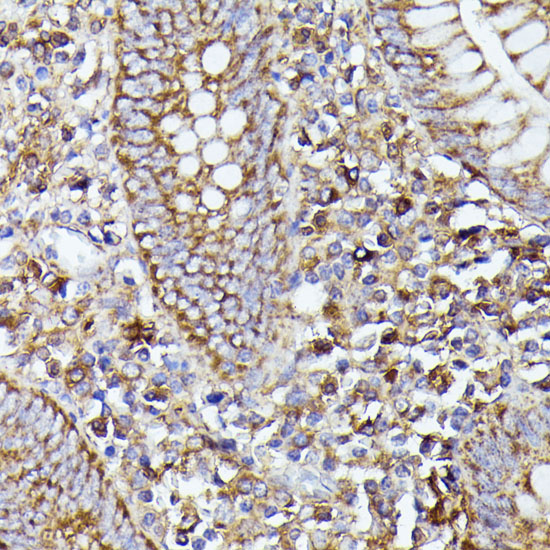

Product Detail
Product NameNLRP3 Polyclonal Antibody
Host SpeciesRabbit
ClonalityPolyclonal
IsotypeIgG
PurificationAffinity purification
ApplicationsWB,IHC,IF
Species ReactivityHuman,Mouse,Rat
Immunogen DescA synthetic peptide of human NLRP3 (NP_001120934.1).
ConjugateUnconjugated
Other NamesNLRP3;AGTAVPRL;AII;AVP;C1orf7;CIAS1;CLR1.1;FCAS;FCAS1;FCU;MWS;NALP3;PYPAF1
Accession NoGeneID:114548
Swiss Prot:Q96P20
Uniprot
Q96P20
Gene ID
114548;
Calculated MW83kDa/105kDa/111kDa/112kDa/115kDa/118kDa
Sdspage MW118kDa
Concentration1.0mg/ml
FormulationPBS with 0.02% sodium azide,50% glycerol,pH7.3.
StorageStore at -20˚C. Avoid freeze / thaw cycles.|Buffer: PBS with 0.02% sodium azide,50% glycerol,pH7.192.
Application Details
WB 1:1000 - 1:3000
IHC 1:50 - 1:200
IF 1:50 - 1:200
Immunofluorescence analysis of Raw264.7 cells using NLRP3 antibody at dilution of 1:100. Blue: DAPI for nuclear staining.
Immunofluorescence analysis of Raw264.7 cells using NLRP3 antibody at dilution of 1:100. Blue: DAPI for nuclear staining.
Immunofluorescence analysis of rat lung cells using NLRP3 antibody at dilution of 1:100. Blue: DAPI for nuclear staining.
Immunohistochemistry of paraffin-embedded rat lung using NLRP3 antibody at dilution of 1:100 .
Immunohistochemistry of paraffin-embedded human appendix using NLRP3 antibody at dilution of 1:100 .
Immunohistochemistry of paraffin-embedded mouse spleen using NLRP3 antibody at dilution of 1:100 .
Western blot analysis of extracts of U-937 cells, using NLRP3 antibody at 1:1000 dilution.
This gene encodes a pyrin-like protein containing a pyrin domain, a nucleotide-binding site (NBS) domain, and a leucine-rich repeat (LRR) motif. This protein interacts with the apoptosis-associated speck-like protein PYCARD/ASC, which contains a caspase recruitment domain, and is a member of the NALP3 inflammasome complex. This complex functions as an upstream activator of NF-kappaB signaling, and it plays a role in the regulation of inflammation, the immune response, and apoptosis. Mutations in this gene are associated with familial cold autoinflammatory syndrome (FCAS), Muckle-Wells syndrome (MWS), chronic infantile neurological cutaneous and articular (CINCA) syndrome, and neonatal-onset multisystem inflammatory disease (NOMID). Multiple alternatively spliced transcript variants encoding distinct isoforms have been identified for this gene. Alternative 5' UTR structures are suggested by available data; however, insufficient evidence is available to determine if all of the represented 5' UTR splice patterns are biologically valid.
If you have published an article using product 29125, please notify us so that we can cite your literature.
et al,The Extracts of Angelica sinensis and Cinnamomum cassia from Oriental Medicinal Foods Regulate Inflammatory and Autophagic Pathways against Neural Injury after Ischemic Stroke. In Oxid Med Cell Longev on 2021 Jun 26 by Cheng Luo, Qi Chen,et al..PMID:34257822
, (2021),
PMID:
34257822
et al,Alpha-lipoic acid alleviates NAFLD and triglyceride accumulation in liver via modulating hepatic NLRP3 inflammasome activation pathway in type 2 diabetic rats. In Food Sci Nutr on 2021 Mar 13 by Chih-Yuan Ko, Yangming Martin Lo, et al..PMID: 34026086
, (2021),
PMID:
34026086
et al,Histone acetylation regulates ORMDL3 expression‐mediated NLRP3 inflammasome overexpression during RSV‐allergic exacerbation miceInJ Cell PhysiolOn2023 DecbyQi Cheng 1, Fanghan He et al..PMID: 37877592
, (2023),
PMID:
37877592
et al,Alleviation of Splenic Injury by CB001 after Low-Dose Irradiation Mediated by NLRP3/Caspase-1-BAX/Caspase-3 AxisInRadiat ResOn2023 Dec 29byChangkun Hu?1?2,?Zebin Liao et al..PMID:?38154483
, (2023),
PMID:
38154483
et al,Dopamine Activates the D1R-Zn2+ Signaling Pathway to Trigger Inflammatory Response in Primary-Cultured Rat Embryonic Cortical NeuronsInCell Mol NeurobiolOn2023 OctbyHui-Chiun Tseng 1, Chien-Yuan Pan et al..PMID: 37289255
, (2023),
PMID:
37289255
et al,Neuritin attenuates neuroinflammation and apoptosis in early brain injury after subarachnoid hemorrhage via endoplasmic reticulum stress-related inflammatory pathways. In Brain Res on 2024 Dec 15 by Kunhao Ren, Linzhi Dai,et al..PMID:39454807
, (2024),
PMID:
39454807
et al,NLRP3 promotes radiation‐induced brain injury by regulating microglial pyroptosis. In Neuropathol Appl Neurobiol on 2024 Jun
by Wan Zhang, Qiheng Wu, et al..PMID:38831600
, (2024),
PMID:
38831600
More
et al,Glutamate Gradually Elevates [Zn2+] i via the CaM− CaMKII− NOS Cascade in Primary Cultured Rat Embryonic Cortical Neurons
, (2024),
PMID:

Yes
Yes



